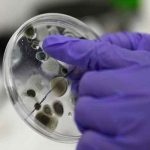
reino unido

Etiqueta: enfermedades infecciosas
Reino Unido anuncia la detección de una nueva cepa de coronavirus
Una nueva mutación del coronavirus, presuntamente procedente de Sudáfrica, ha sido detectada en el Reino Unido, donde se han registrado dos casos de la...
Chile iniciará vacunación contra la covid-19 el 24 de diciembre
Santiago de Chile, 23 dic (EFE).- Chile iniciará la vacunación contra la covid-19 este jueves 24 de diciembre, cuando reciba el primer cargamento de...
Chile: Un estudio revela nueve mutaciones de la covid-19
Santiago de Chile, 22 dic (EFE).- Nueve mutaciones respecto a la cepa china de la covid-19 reveló este martes un estudio del Centro Docente...
Detectan en Bélgica cuatro casos de la nueva cepa de coronavirus
Bruselas, Bélgica | AFP | Cuatro casos de contagio de la nueva cepa del coronavirus fueron detectados en Bélgica a "principios de diciembre", informaron...
Tailandia detecta brote de covid en un mercado de marisco
Bangkok, Tailandia | AFP | Un brote de coronavirus detectado en el mayor mercado de marisco de Tailandia ya ha provocado más de 1.000...
R. Unido: Expertos investigan si la nueva cepa contagia más a los niños
Londres, 22 dic (EFE).- Científicos británicos investigan si la nueva variante del coronavirus se extiende más fácilmente entre los niños, aunque no hay evidencias...
Taiwán detecta su primer contagio local de coronavirus
Taipéi, 22 dic (EFE).- Las autoridades sanitarias de Taiwán informaron hoy del primer contagio por transmisión local del coronavirus SARS-CoV-2 -el causante de la...
Ecuador retoma estado de excepción por la nueva cepa del coronavirus
El presidente de Ecuador, Lenín Moreno, declaró este lunes 21 de diciembre estado de excepción en el país para enfrentar al coronavirus, luego de...
OMS llama a la calma ante mutaciones del covid en R. Unido y Sudáfrica
Ginebra, 21 dic (EFE).- La Organización Mundial de la Salud (OMS) dijo hoy que no hay ninguna evidencia de que la nueva cepa o...
Paraguay alerta sobre pico de infecciones por dengue entre abril y mayo
MONTEVIDEO (Sputnik) — El director de Vigilancia de la Salud de Paraguay, Guillermo Sequera, estimó que el pico de infecciones por dengue se daría...